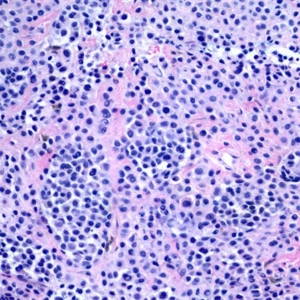

痣样黑色素瘤
Nevoid Melanoma
同义词(或曾用名): 疣状假痣样黑色素瘤
概述:
痣样恶性黑色素瘤是一种小型结节性黑色素瘤态,象痣。
发病部位: 躯干和四肢近端
诊断要点:
常见于中老年病人,常见于躯干和四肢近端,表现为穹窿样丘疹、结节状或疣状;
低倍镜下类似于复合痣或皮内痣,对称性生长,侧向界限清楚;
交界痣样成分少,无 Paget 样扩散现象;
瘤细胞形态一致,温和,似普通痣细胞或 Spitz 痣中的上皮样痣细胞;
病变基底可见局灶片状肿瘤细胞增生,细胞有轻度异型,缺乏成熟现象;
可见核分裂像,包括病理性核分裂像。

免疫组织化学染色:
HMB45 强阳性,Ki-67 指数较高。
鉴别诊断:
结节性黑色素瘤 :细胞高度异型。
